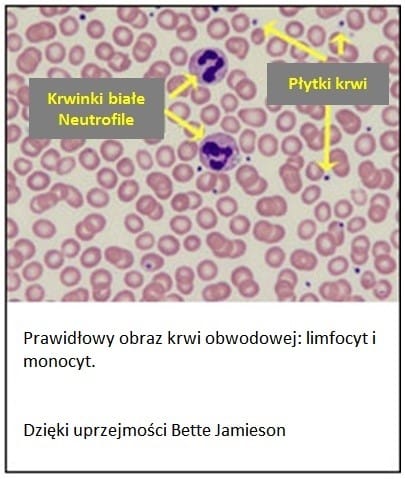

W skrócie
W jakim celu badanie jest wykonywane?
Badanie pomaga określić przyczynę nieprawidłowej liczby WBC; pomaga w rozpoznaniu i monitorowaniu chorób wpływających na układ odpornościowy, takich jak zakażenie lub stan zapalny albo nowotwór, który wpływa na krwinki białe, np. białaczka.
Kiedy badanie jest wykonywane?
Jako część badania morfologii krwi, w ramach rutynowych badań okresowych, kiedy wyniki badania morfologii krwi nie mieszczą się w przedziałach referencyjnych; kiedy występują jakiekolwiek objawy, które można powiązać z zaburzeniami wpływającymi na krwinki białe, takimi jak zakażenia, stan zapalny lub nowotwór; u osób z rozpoznaną chorobą lub poddanych leczeniu, które zmienia liczbę i/lub obraz leukocytów.
Jak się pobiera próbkę do badania?
Pobranie próbki wymaga nakłucia igłą żyły łokciowej lub nakłucia palca, płatka ucha lub – u niemowląt – pięty.
Czy do badania trzeba się przygotować?
Nie.
Informacja o próbce
Co się oznacza?
Krwinki białe (WBC), nazywane też leukocytami, są komórkami krążącymi we krwi i układzie limfatycznym, które uczestniczą w obronie przed zakażeniem. Są ważną częścią układu odpornościowego, odgrywają rolę w stanie zapalnym, odpowiedzi alergicznej, ochronie przed nowotworzeniem. Białe krwinki można podzielić na pięć rodzajów, z których każdy pełni inne funkcje: neutrofile, limfocyty, monocyty, eozynofile i bazofile. Różnicowanie krwinek białych pozwala ocenić, czy te rodzaje krwinek występują w prawidłowych proporcjach, czy krwinek któregoś rodzaju jest za dużo lub za mało oraz czy obecne są krwinki nietypowe lub niedojrzałe. Takie informacje są pomocne przy wykrywaniu określonych chorób, które wpływają na funkcję układu odpornościowego i czynność szpiku kostnego.
Badanie stanowi zwykle część analizy automatycznej morfologii krwi. Może być także wykonane metodą manualną, która polega na mikroskopowej ocenie rozmazu krwi obwodowej przez diagnostę laboratoryjnego lub specjalistę hematologa. Wynik badania przedstawia liczbę bezwzględną poszczególnych typów leukocytów oraz ich zawartość odsetkową w całkowitej liczbie WBC.
Wszystkie rodzaje leukocytów wywodzą się z komórki pnia szpiku kostnego. Dojrzałe komórki obecne we krwi dzieli się na 5 typów:
Granulocyty – komórki z ziarnistościami w cytoplazmie. Ziarnistości zawierają substancje, które są wydzielane przez komórki po pobudzeniu. Granulocyty dzieli się dodatkowo na:
- Neutrofile (granulocyty obojętnochłonne) – w warunkach prawidłowych występują we krwi w największej liczbie. Docierają do tkanek zakażonych lub zmienionych zapalnie, gdzie pochłaniają i niszczą bakterie a czasem grzyby. Młode neutrofile, niedawno uwolnione do krwi ze szpiku kostnego, nazywane są granulocytami z jądrem pałeczkowatym („pałkami”)
- Eozynofile (granulocyty kwasochłonne) – ich odsetek może wzrosnąć z powodu alergii, stanów zapalnych skóry i inwazji pasożytniczych.
- Bazofile (granulocyty zasadochłonne) występują we krwi w najmniejszej liczbie, uważa się, że uczestniczą w odpowiedzi alergicznej.
Limfocyty są obecne we krwi i układzie limfatycznym. Dzielą się na 3 typy, ale w obrazie odsetkowym podaje się liczbę całkowitą limfocytów, gdyż ich różnicowanie wymaga przeprowadzenia badań specjalistycznych. Wszystkie limfocyty wywodzą się z limfoidalnych komórek pnia szpiku kostnego. Trzy typy limfocytów to:
- Limfocyty B, komórki wytwarzające przeciwciała, stanowią istotne ogniwo nabytej odpowiedzi immunologicznej. W pełni dojrzałe komórki B, nazywane komórkami plazmatycznymi, produkują przeciwciała przeciw konkretnym antygenom, które uczestniczą w eliminacji bakterii, wirusów i innych, obcych dla organizmu, antygenów.
- Limfocyty T dojrzewają ostatecznie w grasicy. Wśród nich są komórki pełniące różne funkcje. Niektóre limfocyty T pomagają odróżniać antygeny własne organizmu od antygenów obcych. Inne zapoczątkowują i nadzorują odpowiedź immunologiczną, nasilając ją gdy to konieczne i wygaszają w okresie zdrowienia. Inne w sposób bezpośredni atakują i neutralizują komórki zakażone wirusem lub komórki nowotworowe.
- Komórki NK (nature killers) bezpośrednio atakują i zabijają nieprawidłowe komórki, takie jak komórki nowotworowe i zmienione przez wirusy.
Monocyty, podobnie jak neutrofile, wnikają do zakażonych tkanek, gdzie pochłaniają i niszczą bakterie. Ich zwiększona liczba towarzyszy raczej zakażeniom przewlekłym niż ostrym. Są zaangażowane także w naprawę tkanek oraz pełnią inne funkcje w układzie odpornościowym.
W odpowiedzi na zakażenie lub stan zapalny szpik kostny wytwarza i uwalnia do krwi zwiększoną liczbę leukocytów. Zależnie od przyczyny infekcji lub zapalenia może dochodzić do wzrostu liczby jednego z typów WBC. Gdy choroba wygasa liczba leukocytów i proporcje poszczególnych rodzajów WBC wracają do wartości prawidłowych.
Oprócz zakażenia i zapalenia na wytwarzanie leukocytów w szpiku kostnym i czas ich przeżycia w krążeniu wpływa wiele innych zaburzeń. Wynik różnicowania leukocytów wraz z wynikami innych parametrów morfologii krwi może stanowić sygnał o toczącym się procesie chorobowym. Zwykle wykonywane są badania dodatkowe, m.in. ocena mikroskopowa rozmazu krwi obwodowej, która może ujawnić obecność komórek nieprawidłowych lub młodszych form rozwojowych leukocytów. Obecność takich niedojrzałych komórek może świadczyć o bardzo poważnych chorobach, takich jak zakażenie, białaczka, zespół lub nowotwór mieloproliferacyjny. Do młodszych form rozwojowych zalicza się m.in. metamielocyty, promielocyty i/lub komórki blastyczne.
Nieprawidłowy wynik różnicowania WBC pozwala wykryć zaburzenie. Ustalenie jego przyczyny wymaga zwykle wykonania dodatkowych badań. Lekarz podejmuje decyzję o przeprowadzeniu innych badań uwzględniając objawy, historię medyczną i wyniki badania fizykalnego. W niektórych przypadkach konieczne może być badanie szpiku kostnego.
Badanie
W jakich przypadkach badanie jest wykonywane?
Różnicowanie krwinek białych jako część badania morfologii krwi, stanowi jedno z podstawowych badań w ogólnej ocenie stanu zdrowia. Może także pomóc w wyjaśnieniu przyczyny wzrostu lub spadku liczby WBC. Jest wykorzystywane także w monitorowaniu postępu zaburzeń i chorób, w których dochodzi do zmiany całkowitej liczby WBC lub jednego z typów leukocytów.
Bezwzględna liczba WBC i względna liczba poszczególnych typów komórek jądrzastych (neutrofili, limfocytów, monocytów, eozynofili i bazofili) oraz informacja o obecności komórek nieprawidłowych mogą być przydatne w diagnostyce wielu różnych chorób i zaburzeń. Należą do nich na przykład:
- Zakażenia spowodowane przez wirusy, bakterie, grzyby lub pasożyty
- Stan zapalny
- Alergie, astma
- Zaburzenia o podłożu immunologicznym (np. niedobory odporności, choroby autoimmunologiczne)
- Białaczka
- Zespół mielodysplastyczny
- Nowotwór lub zespół mieloproliferacyjny.
W niektórych schorzeniach odpowiedź układu odpornościowego powoduje wzrost lub spadek określonego typu WBC, co może ułatwić ustalenie rozpoznania, na przykład pomóc w ustaleniu czy zakażenie jest spowodowane przez bakterie czy wirusy.
Inne zaburzenia powodują zmianę wytwarzania komórek przez szpik kostny lub zmianę ich czasu przeżycia w krążeniu, co przejawia się wzrostem lub spadkiem ich liczby. Różnicowanie leukocytów pozwala powiedzieć, którego z 5 typów leukocytów dotyczą te zmiany.
W przypadku nieprawidłowego wyniku różnicowania leukocytów lekarz może zlecić przeprowadzenie następnych badań, takich jak ocena mikroskopowa rozmazu krwi obwodowej, badanie szpiku kostnego lub immunofenotypowanie komórek. Badania te służą do wykrywania i identyfikacji nieprawidłowych lub niedojrzałych komórek jądrzastych we krwi.
W jakich przypadkach badanie jest zlecane?
Obraz odsetkowy krwinek białych zwykle stanowi element badania morfologii krwi. Badanie to zleca się z wielu różnych wskazań, m. in. u osób z objawami zakażenia i/lub zapalenia, takimi jak:
- gorączka, dreszcze
- ból o różnej lokalizacji
- ból głowy
- wiele innych objawów zależnych od miejsca spodziewanego zakażenia lub zapalenia.
Badanie może być zlecone, gdy objawy wskazują na możliwość występowania chorób krwi, zaburzeń autoimmunologicznych lub innych zaburzeń odporności.
Co oznacza wynik?
Wynik badania wskazuje na liczbę i/lub odsetek poszczególnych rodzajów białych krwinek we krwi obwodowej. W przypadku analizy automatycznej mierzona jest bezwzględna liczba poszczególnych typów komórek. W badaniu mikroskopowym najpierw ustala się udział odsetkowy każdego typu komórek w całkowitej liczbie ocenianych komórek jądrzastych, a następnie oblicza ich liczbę mnożąc odsetek przez zmierzoną liczbę WBC. Informacja jest wykorzystywana w diagnostyce i monitorowaniu leczenia wielu chorób.
Interpretacja wyniku różnicowania WBC wymaga rozwagi. Lekarz bierze także pod uwagę zgłaszane przez pacjenta objawy, jego historię medyczną i stopień zmian składu krwinek białych. Trzeba pamiętać, że wiele czynników wywołuje przejściowe zmiany składu odsetkowego. Jeśli zmiana utrzymuje się dłużej, zwykle przeprowadzane są badania dodatkowe, które mają wyjaśnić przyczynę zaburzeń.

W niektórych przypadkach we krwi wykrywane są komórki nieprawidłowe i/lub młodsze formy rozwojowe leukocytów (m.in. metamielocyty, promielocyty i/lub komórki blastyczne). W takiej sytuacji konieczne jest przeprowadzenie innych badań, np. badanie szpiku kostnego.
Uwaga
Dla wielu oznaczeń nie ustalono standardowych zakresów referencyjnych. Ze względu na to, że wartości te zależą od wielu czynników takich jak: wiek, płeć, badana populacja, metoda oznaczenia, wyniki przedstawione jako wartości liczbowe mają różne znaczenie w różnych laboratoriach. Wynik powinien zawierać zakres referencyjny dla konkretnego oznaczenia. Lab Tests Online zaleca, aby pacjent przedyskutował wyniki testu z lekarzem. Dodatkowe informacje na temat zakresów referencyjnych są dostępne w artykule:
Przedziały referencyjne i ich znaczenie.
Co jeszcze należy wiedzieć?
Posiłki, aktywność fizyczna i stres mogą zmieniać obraz odsetkowy krwinek białych.
Długotrwałe przyjmowanie sterydów lub długotrwały kontakt z toksycznymi substancjami chemicznymi (np. z ługiem lub środkami owadobójczymi) zwiększają możliwość nieprawidłowych wyników badania.
Pytania i odpowiedzi
- Czy różnicowanie WBC można przeprowadzić w innym materiale niż krew?
Tak, badanie liczby WBC i różnicowanie krwinek białych można przeprowadzić w innych płynach ustrojowych. Pozwala to na bardziej bezpośrednią ocenę miejsca możliwej infekcji lub stanu zapalnego. Na przykład przy podejrzeniu zapalenia opon mózgowo-rdzeniowych badanie liczby WBC i różnicowanie leukocytów przeprowadza się w płynie mózgowo-rdzeniowym.
- Jakie badania dodatkowe może zlecić lekarz w przypadku nieprawidłowego wyniku różnicowania WBC?
Może to być poszerzony panel metabolitów. Wybór dalszych badań jest zależny od objawów, historii medycznej, wyniku badania fizykalnego. Przykłady testów zlecanych przy podejrzeniu wybranych schorzeń to:
Zakażenie bakteryjne: posiew materiału z odpowiedniego obszaru ciała (np. posiew moczu, plwociny, krwi), szybkie testy paciorkowcowe
Zakażenia wirusowe: badania w kierunku mononukleozy, wykrywanie zakażenia EBV
Stan zapalny: CRP, OB
Choroby autoimmunologiczne: ANA
Alergia: alergenowo-swoiste IgE
Białaczka: biopsja aspiracyjna szpiku kostnego, immunofenotypowanie, analiza chromosomów.
- Co oznacza termin „przesunięcie w lewo”?
Taką informację umieszcza się na wyniku, jeśli we krwi obecne są młodsze, niedojrzałe formy rozwojowe leukocytów. Najczęstszą przyczyną jest zakażenie lub stan zapalny, które powodują zwiększone wytwarzanie komórek w szpiku kostnym i ich uwalnianie do krwi obwodowej zanim osiągną pełną dojrzałość. Jest to przejaw naturalnej odpowiedzi układu odpornościowego na zakażenie lub stan zapalny.
Źródła
Linki do stron obcojęzycznych:
National Institute of Allergy and Infectious Diseases: Immune System
American Society of Hematology: Blood Disorders
Kidshealth.org: Immune System
Kidshealth.org: Infections
MedlinePlus Medical Encyclopedia: Immune Response
National Cancer Institute: Leukemia
